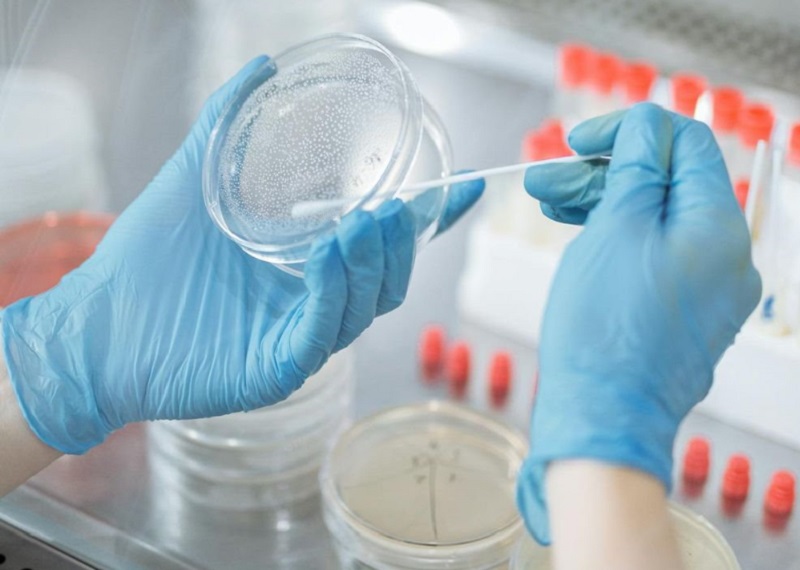
Cuộc truy lùng “bóng ma Heilbronn” -0

Cuộc truy lùng “bóng ma Heilbronn”
Một “nữ sát nhân hàng loạt” bí ẩn, DNA xuất hiện tại hàng chục hiện trường ở Đức và Áo suốt hơn 15 năm, nhưng hóa ra, toàn bộ cuộc truy lùng này là một sai lầm do tăm bông bị nhiễm bẩn. Vụ việc không chỉ khiến cảnh sát lãng phí hàng nghìn giờ, hàng triệu euro, mà còn hé lộ những rủi ro hiếm thấy trong khoa học pháp y hiện đại.
Cô ta từng là một trong những tội phạm bị truy nã gắt gao nhất nước Đức. Mang biệt danh “Bóng ma Heilbronn” và “Người đàn bà không mặt”, cô ta được cho là đã thực hiện một loạt tội ác trên khắp nước Đức suốt hơn 15 năm, bao gồm giết người, đột nhập và trộm cắp. Xét nghiệm cho thấy DNA của cô ta xuất hiện tại 40 hiện trường vụ án. Các điều tra viên buộc phải thừa nhận họ hoàn toàn bế tắc.

“Bóng ma” xuất hiện khắp nơi
Theo Spiegel, DNA được cho là của “bóng ma” được tìm thấy tại hiện trường 40 vụ án ở Đức và Áo từ năm 1993. Kẻ giết người hàng loạt bí ẩn này bị nghi sát hại 6 người, bao gồm một nữ cảnh sát 22 tuổi ở Heilbronn, Đức vào tháng 4/2007. Càng điều tra, cảnh sát càng rơi vào bế tắc. Họ treo thưởng 300.000 euro cho bất kỳ thông tin dẫn đến việc bắt giữ nghi phạm, nhưng vẫn vô vọng.
Trong một diễn biến kỳ lạ, năm 2008, cảnh sát Đức công bố một phác họa nghi phạm. Tuy nhiên, bức phác họa cho thấy đó là một người đàn ông làm dấy lên suy đoán rằng kẻ giết người có thể là người chuyển giới. Trong nhiều vụ án, DNA thu được tại hiện trường cho thấy thủ phạm là một phụ nữ, nhưng nhân chứng lại mô tả một người trông như đàn ông, thậm chí chưa ai từng thấy bóng dáng phụ nữ nào. Càng điều tra, DNA ấy càng xuất hiện ở nhiều hiện trường khác nhau, buộc họ phải bám vào khả năng kỳ lạ này, dù vẫn có điều gì đó không ổn…
Theo tờ National News, mọi việc bắt đầu từ tháng 4/2007, khi một nữ cảnh sát bị bắn chết tại thị trấn Heilbronn ở miền Nam nước Đức. Khi khám nghiệm hiện trường, cảnh sát phát hiện DNA của một phụ nữ trên xe cảnh sát. DNA này trùng khớp với DNA tìm thấy trong hai vụ án mạng chưa phá khác, vụ siết cổ một phụ nữ năm 1993 và một cụ ông năm 2001, đều xảy ra tại các thị trấn phía Nam.

Khi cuộc truy lùng kẻ sát hại đồng nghiệp trở nên ráo riết hơn, cảnh sát Đức bắt đầu kiểm tra tất cả các hiện trường mới, kể cả trộm vặt, để tìm DNA của nghi phạm với hy vọng lần ra dấu vết.
Điều gây đau đầu là DNA của “bóng ma” xuất hiện khắp nơi, trên chiếc bánh quy ăn dở trong căn chòi vườn bị phá, trên ống kim tiêm dùng ma túy vứt bỏ, trên đầu đạn mà một người đàn ông bắn vào họ hàng trong lúc cãi vã và găm vào tường phòng khách. Theo cảnh sát, “bóng ma” còn trộm cả một cây guitar. Ở Áo, DNA của nghi phạm xuất hiện trong 16 vụ trộm cắp.
Trong lúc này, một số điều tra viên có kinh nghiệm thấy vô lý vì trực giác và trải nghiệm cho rằng mô hình tội phạm không khớp, nhưng ý kiến của họ bị phớt lờ. DNA được tin tưởng tuyệt đối, dù nhân chứng của các vụ án không hề trông thấy phụ nữ. Vì vậy, cảnh sát đưa ra kết luận có vẻ “đẽo chân cho vừa giày” rằng thủ phạm có thể trông như đàn ông, thậm chí có thể là người chuyển giới.
Cảnh sát Áo nói họ đã cảnh báo đồng nghiệp Đức rằng có gì đó sai, vì DNA của “người phụ nữ” được tìm thấy trên ngón tay của một thanh niên 21 tuổi bị đánh chết trong vụ ẩu đả. Thủ phạm là nam giới đã bị bắt, và không hề có phụ nữ nào tại hiện trường.
Nghi vấn tiếp tục nảy sinh sau khi DNA của “bóng ma” xuất hiện trong cuộc điều tra về danh tính một thi thể bị cháy được tìm thấy ở Pháp. Thi thể được cho là của một người xin tị nạn mất tích từ năm 2002. Cảnh sát phát hiện người mất tích từng được lấy dấu vân tay khi nộp đơn xin tị nạn. Họ thu được DNA từ dấu vân tay đó và DNA này trùng khớp với DNA của “bóng ma”.
“Rõ ràng điều đó là bất khả thi, vì người xin tị nạn là đàn ông, còn DNA của “bóng ma” thuộc về phụ nữ”, Ernst Meiners, người phát ngôn của văn phòng công tố Saarbrucken, nói. Cảnh sát kiểm tra lần hai và không tìm thấy DNA của “bóng ma” trong mẫu dấu vân tay.
Cuộc điều tra bị làm phức tạp bởi nhiều yếu tố, theo tiến sĩ Linzi Wilson-Wilde, Giám đốc Viện Khoa học Pháp y Quốc gia, Cơ quan Cố vấn Cảnh sát Úc - New Zealand. Những yếu tố đó bao gồm vị trí địa lý rải rác của hiện trường các vụ án. Danh sách những kẻ đồng phạm được cho là của “cô ta” rất lộn xộn, gồm người Slovakia, Serbia, Romania, Albania và Iraq, không theo một mô típ nào rõ ràng. Thậm chí, những người đã bị kết án trong một số vụ đều khẳng định cô ta không tồn tại. Cô ta không xuất hiện trên bất kỳ camera an ninh nào, và một số nhân chứng mô tả cô ta trông giống đàn ông.
Những bằng chứng không kết luận được cuối cùng khiến các điều tra viên phải xem xét lại. “Số lượng và sự đa dạng của các vụ án đã làm dấy lên nghi ngờ về việc vật tư xét nghiệm hiện trường bị nhiễm bẩn”, bà Wilson-Wilde giải thích. Vật chất di truyền của con người có thể vô tình bị truyền sang các thiết bị lấy mẫu pháp y, khiến hàng loạt cuộc điều tra quay lại vạch xuất phát.
Sau đó, tạp chí Stern của Đức đưa tin các tăm bông rất có thể đã bị nhiễm bẩn trong quá trình sản xuất, và suy đoán rằng thủ phạm có thể là một nhân viên bất cẩn tại nhà máy. Dù tăm bông được tiệt trùng trước khi dùng trong điều tra, nhưng tế bào người từ da hoặc mồ hôi vẫn có thể sống sót qua quy trình đó, theo các chuyên gia mà Stern phỏng vấn. Tạp chí này cũng nói rằng mẫu DNA đã được lấy từ các nhân viên nữ của một công ty cung cấp thiết bị y tế tại Đức để so sánh với hồ sơ của “bóng ma”.
Tháng 3/2009, cảnh sát Đức thừa nhận họ đã điều tra theo một hướng hoàn toàn sai lệch do tăm bông bị lỗi dùng để thu thập DNA tại các hiện trường. Mẫu DNA nữ giới này không phải xuất hiện tại hiện trường các vụ án, mà là của một nữ công nhân đóng gói thiếu cẩn trọng tại một công ty sản phẩm y tế ở Bavaria, Đức.
Ngoài ra, Greiner Bio-One, công ty sản phẩm y tế cung cấp lô tăm bông, cho biết các sản phẩm vốn không được thiết kế cho xét nghiệm DNA. “Tăm bông này chỉ phù hợp cho mục đích y tế”, Heinz Schmid, giám đốc công ty, nói tại một cuộc họp báo. Một điều tra viên cảnh sát kể: “Thứ đó được đóng gói hai lớp. Chúng tôi tưởng đó là loại tăm bông “cực phẩm”.
Dù vụ việc này khiến cảnh sát Đức mất mặt, nhưng nó làm nổi bật những vấn đề rất thực tế về rủi ro DNA người nhiễm vào sản phẩm. Sự xâm nhập DNA lạ vào các mẫu tang vật, dù tại hiện trường hay trong phòng thí nghiệm, đều có thể gây hậu quả nghiêm trọng cho một cuộc điều tra.
Nhưng DNA lạ bị đưa vào bằng cách nào? Theo Tổ chức Tiêu chuẩn hóa Quốc tế (ISO), vấn đề nằm ở quá trình sản xuất các vật tư tiêu hao dùng để thu thập và xử lý vật chất DNA. Một quan chức của ISO giải thích: Những vật tư dùng tại hiện trường hoặc trong quá trình xét nghiệm pháp y sau đó là một nguồn tiềm năng gây nhiễm bẩn. “Những năm gần đây, kỹ thuật phân tích DNA trở nên nhạy hơn, dẫn đến việc tạo ra hồ sơ DNA từ những vật tư vốn đã bị nhiễm DNA trong quá trình sản xuất”, ông nói thêm.
Theo một giả thuyết, tăm bông được dùng trong các vụ án được cho là liên quan đến “bóng ma” đều đến từ cùng một nhà máy, nơi có nhiều phụ nữ làm việc và DNA của một trong số họ trùng khớp với DNA thu tại hiện trường một số vụ án. Các tăm bông đã được tiệt trùng đúng quy trình (để tiêu diệt vi khuẩn, nấm và virus), nhưng vẫn bị nhiễm tế bào người dưới dạng mảnh da, mồ hôi, nước bọt hoặc các dịch cơ thể khác.
Sai lầm đáng xấu hổ
Theo National News, vụ việc là một trong những sai lầm lớn nhất và đáng xấu hổ nhất trong lịch sử điều tra hình sự của Đức. Bild, nhật báo bán chạy nhất nước Đức, mô tả vụ việc là “sai lầm đáng xấu hổ nhất của cảnh sát mọi thời đại” và đặt câu hỏi: “Cảnh sát có bông gòn trong đầu hay sao?”. Mặc dù vậy, cảnh sát Đức đã lên tiếng bảo vệ công nghệ DNA, nhanh chóng bác bỏ lo ngại rằng vụ việc này làm tổn hại công cụ then chốt của điều tra hiện đại - phân tích DNA từ tóc, da hoặc máu để lại tại hiện trường.
Giới chức cảnh sát Đức cũng cam kết hợp tác để xây dựng tiêu chuẩn chung trong thu thập bằng chứng pháp y trong tương lai. “Điểm yếu vừa được xác định sẽ dẫn đến cải thiện mang tính quyết định trong việc thu thập bằng chứng,” Klaus Hiller, giám đốc lực lượng cảnh sát hình sự bang Baden-Wurttemberg, nói tại một cuộc họp báo.
Tuy vậy, điều đó khó lòng xoa dịu chỉ trích, xét đến hàng nghìn giờ điều tra bị lãng phí và viễn cảnh hàng chục vụ án phải điều tra lại.

Cơ quan Hình sự Liên bang Đức (BKA), nơi lưu trữ hồ sơ DNA của hơn 620.000 người, đã kêu gọi rà soát các kỹ thuật pháp y để loại trừ nguy cơ ô nhiễm trong tương lai. Vụ việc làm dấy lên hoài nghi nghiêm trọng về độ tin cậy của cơ sở dữ liệu này.
Liên đoàn Điều tra Hình sự Đức (BDK) đã kêu gọi áp dụng một “tem chất lượng DNA” nhằm loại bỏ nguy cơ phân tích sai do nhiễm bẩn. Các nhà sản xuất nên đính kèm dữ liệu DNA của những nhân viên xử lý sản phẩm vào bao bì, phát ngôn viên BDK, Bernd Carstensen, nói với báo Stuttgarter Nachrichten. Điều này cho phép loại trừ DNA của nhân viên hãng sản xuất sản phẩm y tế trong quá trình điều tra. Một hệ thống tương tự đã được áp dụng trong phân tích dấu vân tay để tránh việc cảnh sát vô tình truy lùng chính đồng nghiệp của mình.
Một vật tư bị nhiễm bẩn trong quá trình điều tra không chỉ có khả năng khiến hướng điều tra đi chệch mà còn có thể loại bỏ thủ phạm thật hoặc khiến một người vô tội hoặc một “bóng ma” bị kết án, như trong vụ Heilbronn.
Vụ việc đã gây ra hệ quả sâu rộng với cộng đồng pháp y. Bà Wilson-Wilde cho hay: “Trong vụ ‘Bóng ma Heilbronn’, cảnh sát đã mất 8 năm, tiêu tốn khoảng 2 triệu euro và hơn 16.000 giờ làm thêm để truy tìm một “nữ sát nhân hàng loạt” được cho là liên quan đến hơn 40 vụ án ở Đức, Áo và Pháp”.
Ngoài sự lãng phí hàng nghìn giờ làm việc, còn có hàng chục vụ tội ác tàn bạo mà thủ phạm thật gần như bị bỏ mặc khi các điều tra viên đuổi theo một bóng ma.
“Dù vụ việc này đáng lo ngại, bằng chứng DNA vẫn được xem là một trong những phương pháp đáng tin cậy nhất trong khoa học pháp y, miễn là các thủ tục được tuân thủ đúng. Nhưng từ sự cố này, và nhiều sự cố khác sau đó, rõ ràng rằng ngay cả những kỹ thuật tốt nhất cũng phải đi kèm các tiêu chuẩn quốc tế. Trong khoa học pháp y, không có chuyện “cứ tin tôi đi”, bà Wilson-Wilde nói.
Sau bê bối tăm bông, cảnh sát Đức chuyển hướng điều tra các vụ án và xác định: Nữ cảnh sát Michèle Kiesewetter bị giết bởi các thành viên của nhóm cực hữu NSU. Một số can phạm đã bị bắt và truy tố. Vụ việc tăm bông không chỉ lật tẩy những sai lầm nghiêm trọng trong điều tra pháp y mà còn nhấn mạnh nguy cơ đánh lạc hướng cuộc điều tra và bỏ sót thủ phạm thật.

 Chuyên gia pháp y làm giả xét nghiệm ADN
Chuyên gia pháp y làm giả xét nghiệm ADN